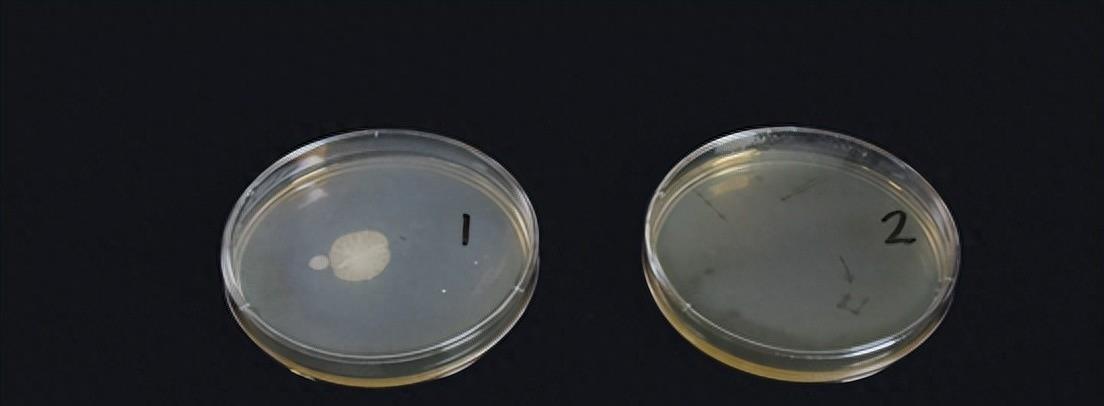
避免甲醛超标选什么家具,亚都能吸附甲醛吗

如何去除甲醛等装修污染?这是一个很重要的问题,因为甲醛不仅对我们的健康有害,还可能引发严重的疾病。在装修过程中,我们经常会接触到甲醛,这是因为甲醛是许多建筑材料的常见粘合剂。尽管有室内空气质量标准的规定,但甲醛在装修后的几个月甚至几年中会缓慢释放出来。所以,怎样才能去除甲醛,保护家人的健康呢?甲醛的存在问题是明确的,那么解决问题的办法是否已经出现了呢?

在市面上,我们可以找到一些空气净化器,它们声称可以去除甲醛。然而,是否每个空气净化器都可以达到这个目标呢?在选择空气净化器时,我们应该注意哪些方面呢?首先,我们需要了解空气净化器的过滤技术。有些空气净化器使用的是HEPA过滤器,它可以有效去除空气中的颗粒物。然而,甲醛是一种气体,对于它的去除,我们需要选择具有活性炭过滤器的空气净化器。活性炭可以吸附甲醛等有害气体,使空气更清新。

其次,我们需要考虑空气净化器的清洁能力。因为甲醛会从家具的孔洞和缝隙中持续释放,所以我们需要一个具有较强清洁能力的空气净化器,能够彻底去除房间内的甲醛。另外,我们还可以采取其他措施来减少甲醛的污染。在装修的过程中,我们可以选择低甲醛的建筑材料和环保涂料,控制甲醛的释放量。此外,定期通风也是非常重要的,可以有效减少甲醛浓度。

总结起来,去除甲醛的关键是选择合适的空气净化器,并采取其他措施来减少甲醛的污染。保护家人的健康,我们不能掉以轻心。如果我们能够采取有效的措施,去除甲醛等装修污染,我们的家将会成为一个健康舒适的环境。最后,我想问读者一个问题:您曾经经历过装修污染的困扰吗?您有什么好的方法来去除甲醛吗?欢迎留下您的评论和分享,让更多人受益。如何有效净化家中的甲醛污染?

开窗通风、装新风机和使用空气净化器是三个可选方案,其中,空气净化器因其便捷和高效备受家庭欢迎。但是,在选择空气净化器时,到底应该看什么?而现在,市场上有太多的品牌和产品,如何选购才能避免受到营销的误导?今天,我们聊一下新品亚都 KJ1000G-T1000,来看看如何选择除甲醛空气净化器,以及了解一下市场上的现状。

甲醛污染治理一直是行业的研究重点,市面上的空气净化器大多使用活性碳吸附甲醛,但后续的测试发现,家庭中甲醛污染是低浓度、缓慢释放的,而活性碳对甲醛的吸附效率比较低。因此,新国标引入了甲醛CADR和甲醛CCM两个指标来衡量空气净化器的甲醛去除效果。其中,甲醛CADR数值越大说明净化速度越快,达到500以上即可有效去除甲醛;甲醛CCM是代表滤芯持续去除污染物的能力,用F级来表示,从低到高一共四级。

那么,回归正题,亚都的新品 KJ1000G-T1000 空气净化器,它的甲醛CADR高达 820,甲醛CCM达到了 F4 级,可以持续去除甲醛。此外,该款空气净化器采用了三重滤网,其中高效HEPA滤网可以捕捉细小颗粒物,除甲醛、异味、雾霾之外,还可去除草履虫等细小病毒。除此之外,亚都 KJ1000G-T1000 空气净化器还具有智能试机功能,方便用户畅快体验。

相比其他品牌产品,亚都 KJ1000G-T1000 的价格也算是相对实惠的。目前,市面上空气净化器品牌和产品数量繁多,有些营销手法让消费者难以分辨,这也导致了市场上的混乱。因此,消费者需要了解甲醛污染的实际情况和选择除甲醛空气净化器的准则,这样才能有的放矢地挑选适合自己家庭的产品。3000块钱,一个空气净化器的关键分水岭!活性炭是除甲醛的主要方法,但价格不菲。

备受关注的亚都的空气净化器KJ1000G-T1000(Hi),究竟能否达到预期效果?让我们一起来看看。在电商上,空气净化器的价格通常是一个重要因素,尤其是3000块钱以下的产品。在这个价格段,除甲醛主要依赖活性炭。然而,活性炭的吸附能力和效率成为了两个关键问题。活性炭的吸附能力有限,滤芯快速饱和后容易释放二次污染物,而且还可能引起发酸问题。

因此,足够多的活性炭是必不可少的,但这也带来了另一个问题——好的活性炭价格昂贵。而在3000元以上的空气净化器中,大部分产品开始采用技术治理甲醛。等离子分解、光催化分解、吸附分解等技术被广泛应用。然而,这些技术要么存在安全隐患,要么无法达到预期效果。另外一种常见的技术是利用催化剂活化空气中的氧气,使其与甲醛反应生成二氧化碳和水。

然而,不同催化剂的性能差异较大,有些需要较高温度或特定温湿度条件才能发挥作用,在室内环境温度下除甲醛效果很差。那么,亚都的空气净化器KJ1000G-T1000(Hi)采用的UFCO技术究竟是什么呢?这款产品究竟能否达到预期效果?让我们一起来进行重点评测。总结起来,3000块钱是选择空气净化器的重要分水岭。价格在这个范围内的产品主要靠活性炭除甲醛,但其中要注意活性炭的吸附能力和效率。

而3000元以上的产品大多采用技术流,包括等离子分解、光催化分解和吸附分解等。然而,这些技术存在安全隐患或无法达到预期效果。另外一种技术是利用催化剂活化氧气来分解甲醛,但不同催化剂的性能差异较大,效果有限。至于亚都的空气净化器KJ1000G-T1000(Hi),则采用了UFCO技术,其效果如何需要经过测试才能得知。你对空气净化器有何看法?你认为除甲醛的最佳方法是什么?

欢迎留言讨论!亚都KJ1000G-T1000(Hi)的UFCO空气净化器,引人注目的亮点在于它采用了具有国内自主知识产权的室温催化氧化甲醛技术和催化杀菌技术。这项被简称为UFCO技术的室温催化效率经过测试表明非常高,因此这款亚都空气净化器不仅可以实现F4级别的甲醛CCM(Clean Air Delivery Rate),还能够提供650m3/h的甲醛CADR(Clean Air Delivery Rate)。

那么,亚都的这款空气净化器又是如何应用这项催化技术的呢?让我们看看它已经进化到第三代的UFCO铂金催化分解甲醛层。通过引入了ⅠA金属催化元素,这个分解层能够加速甲醛的催化氧化分解速度,迅速将甲醛转化为无害的水和二氧化碳,而且这个分解层的寿命是终身可用的,无需更换。此外,还结合了UVC紫外线照射杀菌技术,使得过滤器的结构达到了完美的集大成者的状态。

经过多年的技术迭代、改进和竞争,可以说这款空气净化器的设计已经非常接近最终的成熟状态。这款空气净化器采用双面滤网和3+3滤芯结构,旨在解决各种问题,无论是大颗粒物还是小颗粒物、细菌病毒、甲醛的吸附和分解,它都能应对得当。有了上述的介绍,接下来我们来看一下实际测试的结果。这款空气净化器看起来非常高效,能够在短时间内快速净化空气中的甲醛。

通过测试,它的净化效果非常出色,将甲醛含量从2.321㎎/m3降低到仅有0.004㎎/m3,令人惊叹。不过,虽然它的净化效率高,但它的风量也相应较大,导致噪音较高。对于不在家或刚开始使用的时候可以使用最大档位来快速净化空气。在低浓度甲醛测试中,这款空气净化器同样表现出色。测试中,将劣质复合板材放入密闭展示舱,并进行了长时间观测。

结果显示,在开启空气净化器最小档位后,甲醛浓度一直保持在0.08mg以内,净化效果相当稳定。这对于长期受到甲醛污染的家庭来说,非常重要。建议在这种情况下,将空气净化器始终保持24小时开启状态,以确保持续的净化效果。此外,该空气净化器还配备了一个半导体甲醛传感器,能够多维度监测环境中的污染物,并智能调节净化速度。总的来说,这款空气净化器在净化甲醛方面表现出色,净化效果稳定且功能齐全。

尤其对于长期受到甲醛污染的家庭来说,它是一个很好的解决方案。不仅如此,它还具有睡眠模式,噪音较低,不会带来噪声污【吸引读者】你是否担心家里的空气质量?是否想要一款方便而有效的空气净化器?那么,亚都KJ1000G-T1000(Hi)或许能满足你的需求。它不仅外观时尚,还有着出色的净化能力,为你创造舒适健康的居住环境。【正文梳理】亚都KJ1000G-T1000(Hi)是一款性能优秀的空气净化器。

它采用了双侧进风结构和同体双涡轮增压的发动机,能够实现更好的空气循环效果。同时,它还配备了净化指示灯,让你能够直观地了解房间内的污染状况。这款净化器不仅能够除去颗粒物污染,还具有良好的除菌能力。为了验证净化器的除菌效果,我们进行了一项实验。我们在1立方米的仓内放入了腐败长毛的草莓和两只细菌培养皿,经过48小时的培养,结果显示,净化后开启的培养基内没有任何细菌,而对照组却出现了很明显的细菌点。
这表明亚都KJ1000G-T1000(Hi)在除白色葡萄球菌、人冠以及甲流等多种病毒方面具有显著的功效。【总结部分】长期使用空气净化器,对于改善室内空气质量有着明显的效果,而亚都KJ1000G-T1000(Hi)正是一款可靠的选择。它的稳定性、质量和净化能力堪称一流。不仅如此,它的外观和功能也都非常出色,让你在使用的过程中能够更加方便和舒适。

综上所述,如果你在寻找一款高效而方便的空气净化器,不妨考虑亚都KJ1000G-T1000(Hi)。它能够有效净化污染物,为你打造一个健康宜居的家居环境。现在就行动起来,让亚都的空气净化器成为你家的守护者!【引导评论】你家里使用过空气净化器吗?有没有遇到过什么问题?请留下你的宝贵意见和建议,我们期待与你分享。想要呼吸到清新的空气,如何选择一款符合自己需求的空气净化器?

亚都KJ1000G-T1000(Hi)可能是值得你放眼的一款产品。它能够高效地净化室内空气中的细菌、病毒、有害气体等污染物,让你的呼吸更加轻松畅快。如果你的家里有多个房间或者户型相对小一些,那么同系列的KJ550F-T550(Hi)也许更适合你,你可以单独使用一台,或者组合使用多台放置在不同的房间。
同时,如果你需要对室内湿度进行调节,那么带有加湿功能的KJ800G-P8H55可能更适合你,特别是对于需要额外呵护的母婴人群。选择一款合适的空气净化器并非易事,因为市场上的产品种类繁多。但是,在我们的评测中,亚都净化器系列的表现却相当出色。它们不仅拥有强大的净化能力,而且采用智能控制技术,在不同的环境中能够自适应运行,最大限度地保障家庭空气质量的整体改善。
如果你需要一台空气净化器,亚都净化器系列是一个不错的选择。综上所述,根据你的实际需求,可以选择不同功能和价格的亚都净化器系列产品。质量有保证,价格实惠,物有所值。你需要考虑的是,选择一款适合你家庭的空气净化器,会促使你和家人的生活更加健康舒适。那么,你是否已经选择了适合自己的亚都净化器呢?欢迎在下方留言,和我们分享你的想法。